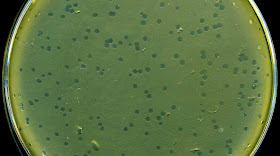

|
| Cassandra Quave bridges traditional and modern medicine as an ethnobotanist, studying human interactions with plants. |
By Carol Clark
Cassandra Quave was first immersed in the battle against infectious diseases when she was 3 years old and hospitalized with a life-threatening case of staph.
“That’s probably why I feel a strong connection to people who deal with these kinds of infections,” says Quave, a graduate of Emory College who is now a visiting assistant professor at Emory’s
Center for the Study of Human Health.
Quave just received a $1.8 million grant from the National Institutes of Health to pursue her research into how an extract from a tree common in forests across Europe might help fight antibiotic-resistant staph. The five-year project led by Quave will include collaborators from the
Emory Institute for Drug Development, the University of Iowa and Montana State University.
She notes that prolific use of modern drugs in our society helped turn multi-drug resistant
Staphylococcus aureus (MRSA) into the leading cause of invasive disease in the U.S., killing more people every year than AIDS. And the remedies of traditional healers may lead to better ways of treating it.
Quave draws from the knowledge of rural people like 82-year-old Donato Sabato of Italy, who uses Malva sylvestris stems to treat stomachache. Photo by Cassandra Quave.
“Ideally, we should combine the best of both modern medicine and complementary alternative medicine,” says Quave. She bridges the two worlds as a medical ethnobotanist, studying human interactions with plants.
At 34, Quave already has a utility patent for one promising medicinal plant extract, and has filed a disclosure for a second patent. In 2011, she formed the bio-venture startup PhytoTEK with a friend from Harvard Business School, Sahil Patel, who is also an Emory alumnus. PhytoTEK advanced to the final round of the Harvard Business School’s Alumni New Venture Contest, placing in the top three of the global finals.
The unusual career of Quave (rhymes with “wave”) has been forged by everything from interviewing native healers in the Peruvian Amazon to undergoing dozens of major medical procedures in the United States.
She grew up in the small town of Arcadia, in a rural area of South Florida, where her mother was a teacher and her father ran a land-clearing business for agriculture. She had multiple congenital birth defects of her skeletal system, including missing part of her right calf bone. When she was 3, her right leg was amputated below the knee in an effort to improve her mobility.
“The doctors told my mother not to unwrap the bandages, but she noticed this horrible stench coming from my leg and knew that something wasn’t right,” Quave says. “As she took off the bandages, the flesh just fell off the bone. It was almost liquefied.”
 |
| Quave in the hospital, after the amputation of her lower right leg. |
The toddler returned to the hospital for treatment of a severe staph infection. “I had to spend a very long time in the hospital,” she recalls. “I remember the nurses putting me in a bright-red bath of Betadine. I thought it was blood.”
Her leg had to be cut off even shorter, leaving her with a heavily scarred stump that lacks fatty tissue, making prosthetics less comfortable.
A neighbor later told Quave that she had felt sorry for her when she was a little girl and watched her struggle to climb the ladder of a slide. The neighbor thought it was terrible that Quave’s mother saw her daughter cry from the effort, and didn’t go and help.
“I’m so glad my parents had the strength not to help me do everything,” Quave says. “That made me independent. It takes a special person to raise a disabled child.”
 |
| Quave at work in the Amazon. |
Like many kids, Quave enjoyed playing in the dirt or climbing a tree to be alone with a good book. During high school, she learned to operate the bulldozer and backhoe parked in the family’s yard, so she could help with her father’s business on summer breaks. Curiosity was her constant companion. She excelled in science fairs, competing at the state and international level. For her first science project, in the sixth grade, she took saliva samples from her dog, a horse and a cow for a comparative analysis.
Nearly every year as she grew up, Quave had to return to the hospital to have her leg re-operated on. The bone had to be filed down as it kept growing out the end of the stump. She later made history as one of the first amputees to have bone lengthening surgery. “They broke my femur and implanted a kind of knob that you twist,” Quave explains matter-of-factly.
At 13, she developed scoliosis. Metal rods were surgically implanted in her back. She also had hip dysplasia, requiring her pelvis to be broken and rebuilt.
One silver lining to her slew of medical problems was pediatric orthopedist Chad Price, who also happens to be an Emory alumnus. He performed almost every surgery on Quave, except for the initial leg amputation, and became a friend and mentor that Quave still consults.
“I was a very odd, inquisitive kid, and Dr. Price took the time to listen to me and answer all of my questions,” Quave says. “He is different from most surgeons, he’s almost like a traditional healer in the way that he connects with patients,” she adds. “I remember once when I was coming out of anesthesia, and I was crying because it hurt so much. Dr. Price lay down in the bed next to me and held me.”
The metal rods implanted in Quave’s spine had to be removed after she had a bad reaction to them and her back became inflamed. Quave told one of the medical residents who saw her before surgery that she wanted the operation filmed.
“He thought that was a really strange request and said, no, but then Dr. Price said, ‘Sure, we’ll do that for you.’ I still have the VHS tape at home. It was fascinating to me, to see them chisel these rods out of my back.”
 |
| "I have as
much respect for the best traditional healers as I do for the top
scientists at Emory," says Cassandra Quave, right, in the Peruvian
Amazon as an undergraduate at Emory. |
During the 8th grade, Quave started volunteering at the local hospital’s emergency room. “I would spend Friday and Saturday nights watching doctors perform procedures in this small-town E.R. I’d make sure the patients were comfortable, bring them blankets and things,” she recalls. “I definitely had a gift for communicating with people who were sick.”
When her mother insisted that she get home before 2 am, Quave recalls arguing, “That’s when all the good drug cases and bar fights start coming in.”
Following in the footsteps of Price, Quave got her undergraduate degree at Emory, where she majored in biology and anthropology. She planned to go on to medical school and become an orthopedic surgeon. But a different path opened up when she took a tropical ecology class from
Larry Wilson, an adjunct faculty in
Emory’s department of environmental studies and an ecologist at Atlanta’s Fernbank Science Center. Under Wilson’s tutelage, Quave spent several months in the Peruvian Amazon, researching the therapies of traditional healers.
“You can learn a lot by listening to those people,” Quave says. “I have as much respect for the best traditional healers as I do for the top scientists at Emory.”
 |
| Traveling by boat through the Amazon. Photo by Cassandra Quave. |
Quave’s leg became inflamed and infected from the rough walking on the jungle trails, but she had come prepared with antibiotics. She treated her leg and simply walked less, switching to small riverboats to travel amid the mestizo communities.
Many of the children had swollen bellies and stunted growth, telltale signs of intestinal worms. A traditional healer explained to her how the white latex from a fig tree could be made into a remedy to purge worms.
The Peruvian government, however, had installed medicine chests in the remote communities, stocked with treatments for parasites and other ailments. Eventually, the supplies were used and not replenished. Meanwhile, the traditional healers had stopped training apprentices because people preferred the stronger drugs to the older ways.
“I would see all these kids with swollen bellies, and a fig tree right in the middle of the village, but no one knew how to prepare the treatment,” Quave says. “It’s a great example of why we have to understand both sets of knowledge – modern and traditional.”
 |
| A Peruvian healer shares his knowledge. Photo by Cassandra Quave. |
She uses the term “complementary alternative medicine,” or CAM, adding: “There is a reason it’s called ‘complementary.’ It doesn’t have to be just one or the other.”
An acceptance letter from a medical school was waiting for her when she returned to Atlanta during her senior year at Emory, but the Amazon had changed Quave. She no longer wanted to be an MD. A chance meeting with an Italian ethnobiologist at a conference led Quave to Southern Italy, where she conducted field research into the traditional remedies of rural people there.
She wrote a sort of
“cookbook” of traditional medicine of the region. The volume, penned in English and Italian, and full of gorgeous photographs, aims to conserve both the local knowledge and the natural environment.
 |
| A weed to one person is medicine to another. |
Quave also fell in love while in Italy. She married Marco Caputo, a resident of the tiny town of Ginestra, and they now have two young children. “It’s funny how fate works,” she says.
Back in the United States, Quave pursued a PhD in biology at Florida International University, where she focused on an ethnobotanical approach to drug discovery. “I felt strongly that people who dismissed traditional healing plants as medicine because the plants don’t kill a pathogen were not asking the right questions,” she says. “What if these plants play some other role in fighting a disease?”
She led a project to analyze extracts from 100 different species of plants that she had collected in Italy, guided by clues from hundreds of interviews with local people and healers. She was particularly interested in finding treatments for skin and soft-tissue infections, to help in the fight against MRSA.
This “super bug” bacterium can cause everything from mild skin irritation to death. MRSA is difficult to treat because it is constantly adapting, and has become resistant to many antibiotics. It is now common in people with weak immune systems in hospitals and nursing homes. People with implanted medical devices, like knee or hip replacements, are especially at risk since the implants provide a smooth surface that the sugary matrix of the bacteria likes to adhere to.
In 2005, the CDC reported that MRSA was responsible for an estimated 94,000 life-threatening infections and 18,650 deaths, and the rates have kept rising since then.
 |
| Rubus ulmifolius, or the elm leaf blackberry, is one plant that shows promise for treating MRSA. |
Even more alarmingly, MRSA infections are on the rise in healthy, young people outside of hospitals. Those who share close quarters and have skin-to-skin contact, such as football players, are at higher risk.
Quave is uncovering promising new ways to treat MRSA by teasing apart leaves, stems, roots and bark, isolating individual plant compounds for analysis. Her first patent involves a compound from the roots of an Italian elm leaf blackberry that neutralizes the staph defense system.
“Think of it like Star Trek,” she says, explaining that after MRSA attaches to something, it can grow a biofilm that acts like a shield against antibiotics, much like a villainous space ship uses a force field to ward off weapons of the Starship Enterprise. The plant extract prevents the MRSA bacteria from attaching to anything, so it can’t throw up a force field.
Quave hopes that the extract could one day be used to coat artificial implants and catheters before they are surgically implanted, preventing MRSA from ever gaining a foothold on them.
The recent NIH grant Quave received will further her research into a second compound from a European tree. This compound, which she is identifying only as “Extract 134” until a utility patent is filed, inhibits the toxic effects of MRSA.
 |
| An Albanian woman tells her plant stories. |
“One reason that MRSA can infect healthy people is that it’s really good at producing a ton of toxins that it shoots out like lasers to cause tissue damage,” Quave says. “Extract 134 turns off the MRSA system responsible for toxin production. The bacteria is still able to grow, but its weapons are turned off.”
Taking away MRSA’s tissue damaging weapons, and/or its force field, could tip the battle back into the favor of the host’s immune system, with little, or no, help from antibiotics, Quave theorizes.
“It’s more of a delicate approach. The goal is to improve patient therapy, reduce infection rates, and avoid creating more virulent strains of MRSA,” she says.
After a post-doctoral stint at the University of Arkansas for Medical Sciences, Quave joined Emory last fall. She was recruited by another one of her long-time mentors,
Michelle Lampl, a physician and anthropologist who heads Emory’s
Center for the Study of Human Health. Lampl founded the center last year to serve as a nexus of Emory’s diverse assets in health education, research and practices. The aim is to foster exchange among scholars whose interests span the scientific, social and cultural dimensions of health and well-being.
Quave teaches a course on medical botany while also pursuing her drug discovery research that will tap expertise from anthropology, biology, chemistry and environmental studies. “I have my finger in a lot of pies,” Quave says, “so I tend to bring together a lot of different people who might not normally mix.”
Many hurdles remain to getting the plant-based MRSA treatments from the laboratory into clinical trials, but Quave is undaunted. “I’m used to obstacles,” she says. “I’ve climbed a lot of brick walls in my life.”
All photos courtesy of Cassandra Quave.
Related:
Acai berries can lengthen lives of fruit flies
Monarch butterflies use medicinal plants
Emory's starvine: A rare plant clings to campus
The dark lore of Deadly Nightshade